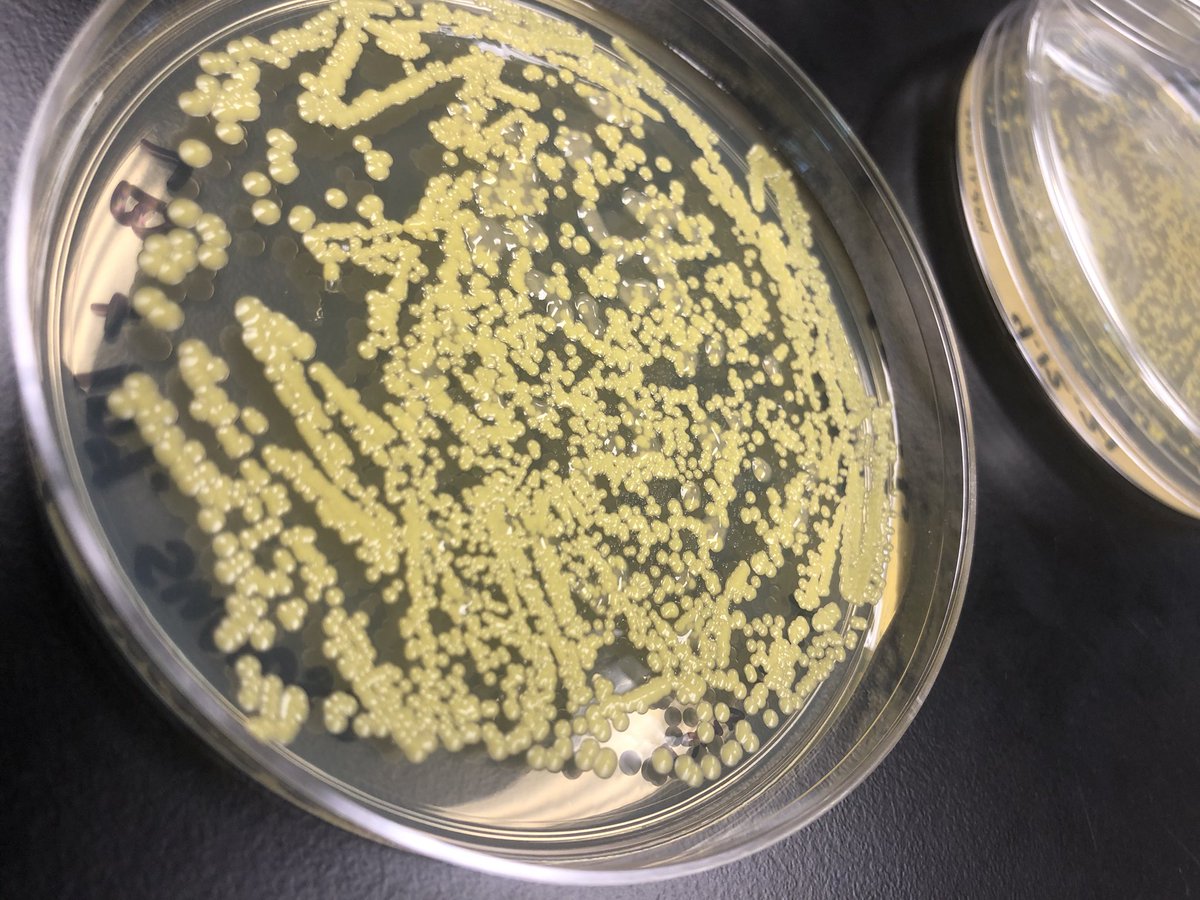
HCChen_Johnny's tweet image. Oops I’ve never thought the contamination would be such a big issue for me.....these bastards literally grew “on” my colonies 😂
#bacteriology #Labclass

#labclass search results
Happy #1stdayofschool to everyone from Preschool-Grade12! What a special day! ...and another #1st for the students of our very 1st #labclass! Class 9b will focus on #projectbasedlearning with extracurricular partners - a few days per week on our MV Campus and a few days in SF.

TBT @USCPrice @USCinDublin Trimm Castle in honor of St. Pat (& Braveheart film) #international #labclass #memories

When working with 2 guys on your group project and they barely text you ...... this project is due Monday #labclass #boys #lordhelpme 🙄
K-2 Literacy Lab Classroom at @ih_jaguars: 10 teachers and 30 students committed to getting better for themselves and each other #labclass #earlylit #pd #OtherPeopleMatter #WeAreGB @GBCSBobcats




Lab class today for our Cellular Patology students following up from their lecture on disease and surgical procedure earlier in the week #labclass #biomedicalscience #IBMS




Germán Fariña reivindica a importancia e a necesidade da dixitalización da agricultura sobre 3 pilares: cambios na alimentación, reducir desperdicios na cadea de alimentación e aumentar a producción de alimentos para abastecer a demanda crecente @escuelainventa #LabClass

This afternoon was equally fantastic with @chiagirl30 and the first grade Dual Teachers! #readersworkshop #labclass @RRSPrincipal @SDL220 @BeckyWiegel @barrington220





In their science lab sessions, SAIoneers from Class V, embarked on an enriching journey of experiential learning. They explored the characteristics of opaque, transparent, #ExperientialLearning #LabClass #LightAndShadows




Happy #1stdayofschool to everyone from Preschool-Grade12! What a special day! ...and another #1st for the students of our very 1st #labclass! Class 9b will focus on #projectbasedlearning with extracurricular partners - a few days per week on our MV Campus and a few days in SF.

🌅🥼🌌 Summer #MIP 302 General Microbiology Lab students had the added fun of tie-dying their lab coats! #Microbiology #LabClass #CSUSummer #UndergradIntheLab #TieDye #TieDyeLove #ColoradoState

Love this. #proteinFolding #Alphafold #labClass #learning #biotech #DIY
For my latest attempt at introducing proteins to students, I made a Google Colab Notebook that predicts proteins from a single sequence. I asked the students to tweak the sequence to get a helix or two helices or... (1/5) colab.research.google.com/github/sokrypt…

Lab class today for our Cellular Patology students following up from their lecture on disease and surgical procedure earlier in the week #labclass #biomedicalscience #IBMS




Working on that lab write from earlier in the semester and don't remember important details and can't find your notes. We can help with our Student Resource Center bit.ly/3ryfOOQ #labclass #sciencemajor #Biology #Biochemistry

Quick cloning tip. Make colony picking easier by putting your plates at 4C for a bit, picking the right colonies will be so much easier. bit.ly/3DwZ4dU #sciencelab #labclass #hellophd #microbiology #biochemistry

Thanksgiving is a little over a week away in the US. Need to wrap up some lab writeups before break but forgot what you did? Check out these refreshers bit.ly/3CiyaVV #laboratory #labclass #labwriteup #biolab #nucleicacid

Oops I’ve never thought the contamination would be such a big issue for me.....these bastards literally grew “on” my colonies 😂 #bacteriology #Labclass

Seguimos emocionándonos en esta #LabClass de @escuelainventa, ahora con Marta Sixto “Sobre todo amor”

Happy #1stdayofschool to everyone from Preschool-Grade12! What a special day! ...and another #1st for the students of our very 1st #labclass! Class 9b will focus on #projectbasedlearning with extracurricular partners - a few days per week on our MV Campus and a few days in SF.

Something went wrong.
Something went wrong.
United States Trends
- 1. Thanksgiving 363K posts
- 2. Golesh 1,879 posts
- 3. Fani Willis 10.8K posts
- 4. Trumplican 2,679 posts
- 5. Hong Kong 76.1K posts
- 6. Khabib 6,108 posts
- 7. stranger things 155K posts
- 8. #WipersDayGiveaway N/A
- 9. Riker N/A
- 10. #TejRan 3,960 posts
- 11. Ruth 13.3K posts
- 12. Elijah Moore N/A
- 13. Tom Hardy 1,081 posts
- 14. Pete Skandalakis N/A
- 15. NextNRG Inc N/A
- 16. #Wednesdayvibe 3,529 posts
- 17. #sstvi 44.8K posts
- 18. Nuns 10.3K posts
- 19. #wednesdaymotivation 6,610 posts
- 20. Karoline Leavitt 27.5K posts
























































![browniiesawyer's profile picture. «Looks like a girl, but she's a flame. So bright, she can burn your eyes; better look the other way» [IG: ritabrigadeiro | we♥it: riitzz]](https://pbs.twimg.com/profile_images/378800000202357561/fcc70d13099b88542d5010378698c2bf.jpeg)





